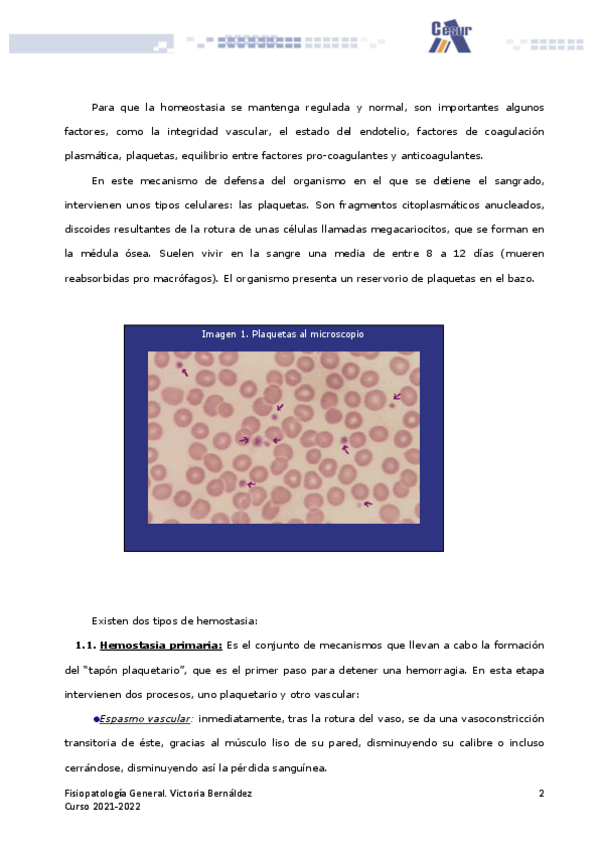

Fisiopatología general
He publicado nuevos apuntes de Fisiopatología general: Sostenibilidad-Tema-2.pdf
He publicado nuevos apuntes de Fisiopatología general: Sostenibilidad-Tema-1.pdf
He publicado nuevos apuntes de Fisiopatología general: Tema-10-SISTEMA-RENAL-Y-URINARIO.pdf
He publicado nuevos apuntes de Fisiopatología general: Tema-9-Sistema-respiratorio.pdf
He publicado nuevos apuntes de Fisiopatología general: Tema-8-Sistema-digestivo.pdf
He publicado nuevos apuntes de Fisiopatología general: Tema-7-Hemostasia-y-coagulacion.pdf
He publicado nuevos apuntes de Fisiopatología general: Tema-6-Sistema-circulatorio.pdf
He publicado nuevos apuntes de Fisiopatología general: Tema-4-Enfermedad-infecciosa.pdf
He publicado nuevos apuntes de Fisiopatología general: Tema-3-Inmunologia-celular.pdf
He publicado nuevos apuntes de Fisiopatología general: Tema-2-Identificacion-del-proceso-de-desarrollo-de-la-enfermedad.pdf
He publicado nuevos ejercicios de Fisiopatología general: DOSSIER-ACTIVITAT-Sistema-immunitari-SI.pdf
apuntes
-
fisiopatologia
He publicado nuevos apuntes de Fisiopatología general: fisiopatologia
He publicado nuevos trabajos de Fisiopatología general: Cambios-en-el-ciclo-menstrual.pdf
He publicado nuevos trabajos de Fisiopatología general: Cancer-de-cuello-uterino.pdf
He publicado nuevos apuntes de Fisiopatología general: La-tuberculosis.TRABAJO6
He publicado nuevos apuntes de Fisiopatología general: Trabajo-Cancer-de-Mama.TRABAJO7
He publicado nuevos apuntes de Fisiopatología general: TEMA-10.-Alteraciones-de-la-nutricion-y-el-metabolismo.pdf
He publicado nuevos apuntes de Fisiopatología general: Fisio-UT-11-Enfermedades-Infecciosas-1.pdf
He publicado nuevos apuntes de Fisiopatología general: FISIO-UD15-Fisiopatologia-Aparato-Respiratorio-y-Circulatorio.pdf
He publicado nuevos apuntes de Fisiopatología general: FISIO-UD18-Trastornos-Hemodinamicos-y-Vasculares.pdf
He publicado nuevos apuntes de Fisiopatología general: TEMA-9.-Fisiopatologia-respiratoria-y-digestiva.pdf
He publicado nuevos apuntes de Fisiopatología general: TEMA-7.-Fisiopatologia-neurologica-y-endocrina.pdf
He publicado nuevos apuntes de Fisiopatología general: TEMA-8.-Fisiopatologia-vascular-y-hemodinamica.pdf
He publicado nuevos trabajos de Fisiopatología general: Trabajo-Fisiopatologia.pdf
He publicado nuevos apuntes de Fisiopatología general: Esquemas U7 - Fisiopatología neurológica y endocrina.pdf
He publicado nuevos apuntes de Fisiopatología general: T5-ESQUEMA-SISTEMA-INMUNE.pdf
He publicado nuevos apuntes de Fisiopatología general: TEMA-5.-Enfermedades-infecciosas.pdf
He publicado nuevos apuntes de Fisiopatología general: TEMA-6.-Las-enfermedades-neoplasicas.pdf
apuntes
-
Fisiopatología
He publicado nuevos apuntes de Fisiopatología general: Fisiopatología
He publicado nuevos apuntes de Fisiopatología general: TEMA-4.-FISIOPATOLOGIA-DEL-SISTEMA-INMUNITARIO.pdf
He publicado nuevos apuntes de Fisiopatología general: TEMA-3.-LA-PATOLOGIA-Estudio-de-la-enfermedad.pdf
He publicado nuevos apuntes de Fisiopatología general: ACTIVIDAD-TEMA-5-FIS.pdf
He publicado nuevos apuntes de Fisiopatología general: Fisiopatologia-UF2-Fisiopatologia-del-sistema-inmunitario-infecciones-y-neoplasias.pdf
apuntes
-
FISIOPATOLOGÍA
He publicado nuevos apuntes de Fisiopatología general: FISIOPATOLOGÍA
He publicado nuevos apuntes de Fisiopatología general: Que-es-la-ateroesclerosis.pdf
He publicado nuevos trabajos de Fisiopatología general: Enfermedad-de-crohn.pdf
He publicado nuevos trabajos de Fisiopatología general: Alimentacion-y-nutricion.pdf
He publicado nuevos trabajos de Fisiopatología general: Trastornos-alimenticios.pdf
He publicado nuevos trabajos de Fisiopatología general: Modelo-de-las-9-areas.pdf
He publicado nuevos ejercicios de Fisiopatología general: Mapa-conceptual-celula T2.pdf
He publicado nuevos apuntes de Fisiopatología general: Tema 5 (Ej. 1-15).pdf
He publicado nuevos ejercicios de Fisiopatología general: Tema-5-Ej.-16-36.pdf